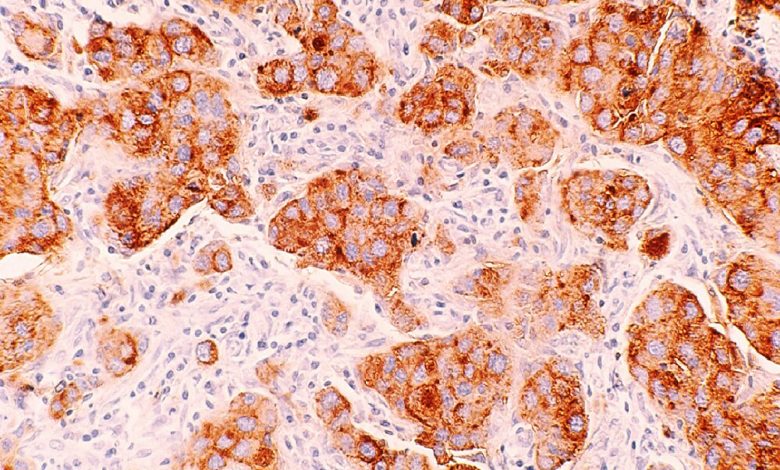

داروی فشار خون توانست تومور سرطان پستان را در موشها کوچک کند
بررسی جدید پژوهشگران چینی نشان داده است که داروی رایج ضد فشار خون «لاسیدیپین» میتواند رشد تومور را در مبتلایان به سرطان پستان سهگانه منفی کاهش دهد.
به گزارش پایگاه خبری اخبارخوب به نقل از ایسنا، پژوهشگران «موسسه زیستشناسی چنگدو»(CIB) دریافتهاند که داروی فشار خون «لاسیدیپین»(lacidipine) میتواند به عنوان یک درمان برای سرطان پستان سهگانه منفی عمل کند.
به نقل از ادونسد ساینس نیوز، اگرچه تنها حدود ۱۰ درصد موارد سرطان پستان از نوع سهگانه منفی هستند اما این تهاجمیترین نوع سرطان پستان است که اغلب در مراحل پایانی تشخیص داده میشود و به سایر قسمتهای بدن سرایت میکند یا پس از درمان اولیه بازمیگردد. درمان این بیماری به دلیل مقاومت آن در برابر داروهای رایج شیمیدرمانی و عدم پاسخگویی به درمان هورمونی بسیار دشوار است.
«فی وانگ»(Fei Wang) سرپرست این پژوهش گفت: آزمایشهای بالینی که شیمیدرمانی را با داروهای هدفمند ترکیب میکنند، نتوانستهاند بهبود قابل توجهی را در بقا نشان دهند.
این پرسش برای وانگ و گروهش پیش آمد که آیا داروهای فشار خون موثر بر مهار سرطان روده بزرگ و سرطان پوست میتوانند برای درمان سرطان پستان سهگانه منفی نیز استفاده شوند.
به نظر وانگ، داروهای طراحیشده برای تنظیم فشار خون ممکن است با تداخل در مسیرهای متابولیکی که به تومورها اجازه رشد و گسترش میدهند، بر سلولهای سرطانی نیز تأثیر بگذارند. وی افزود: فشار خون بالا و عوارض سرطان، مسیرهای بیولوژیکی یکسانی دارند.
این روش جدید میتواند راه را برای درمانهای مؤثرتر سرطان پستان سهگانه منفی به ویژه در مواردی که درمانهای مرسوم شکست خوردهاند، هموار کند.
وانگ خاطرنشان کرد که پیش از آزمایشهای بالینی، لاسیدیپین باید روی ارگانوئیدها و مدلهای حیوانی سرطان پستان با فشار خون بالا آزمایش شوند. وی افزود: آزمایش این دارو در مدلهایی از انواع دیگر سرطان به گسترش کاربردهای بالینی احتمالی و تقویت نقش آن به عنوان یک عامل ضد سرطان کمک میکند.
همچنین، وانگ خاطرنشان کرد که برخی از درمانهای سرطان از جمله داروهای شیمیدرمانی، فشار خون را افزایش میدهند و درمان ترکیبی با داروهای فشار خون، اثر آنها را بهبود میبخشد.
وانگ گفت: لاسیدیپین ممکن است به طور موثر به مدیریت این عارضه جانبی بپردازد و از تأثیر بیشتر فشار خون بر نتایج درمان یا ایجاد مشکلات قلبی-عروقی بیشتر جلوگیری کند.
این پژوهش در مجله «Advanced Science» به چاپ رسید.
انتهای پیام